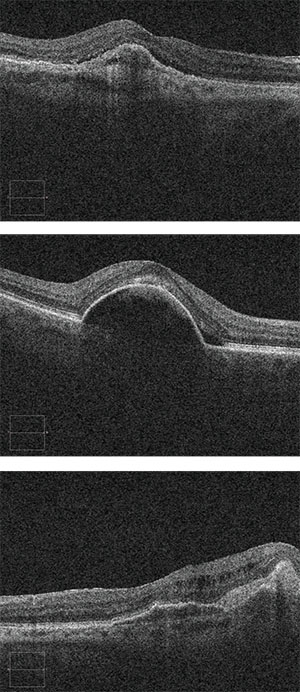

| Dr. Reed is with Ophthalmic Consultants of Boston. He has received a research grant from Regeneron. Dr. Regillo is with Mid-Atlantic Retina and the Retina Service of Wills Eye Hospital, Philadelphia. He has received research grants from Genentech, Regeneron, Allergan, Alcon, Ophthotech and Iconic, and has done consulting for Genentech, Regeneron, Allergan, Alcon and Iconic. Dr. Heier is co-president of Ophthalmic Consultants of Boston. He has received research grants from Regeneron and Genentech, and had done consulting for Regeneron, Genentech, Heidelberg and Optovue. |

Nuts and Bolts of TAE
Dr. Reed: Dr. Heier, can you please briefly outline the TAE regimen?
Dr. Heier: When using TAE, an injection is given at every visit, whether or not signs of active exudation are present. Treatment typically begins with monthly injections. If persistent signs of active disease are present, injections continue monthly until the macula is dry.
Once the macula is dry, the interval between injections is increased incrementally, often at one- to two- week intervals. If the exudation does recur, the interval between injections is reduced, thus finding the maximum interval that results in a dry macula.1 Although the best results from the highest-quality data show that fixed monthly, or bimonthly in the case of aflibercept (Eylea, Regeneron), injections give the best visual results,2-4 66 percent of retina specialists in the United States use TAE5 because they believe it rationally balances the goals of achieving good visual outcomes and reducing the number of injections given.
Dr. Reed: Many studies of TAE have used three monthly loading doses before attempting an extension. Dr. Regillo, do you use loading doses in your practice?
Dr. Regillo: I’ll extend the first time I think the macula is dry or at its best. I take into account the vision, the exam, the optical coherence tomography findings—all the data I gather at that encounter. Nobody has ever proven that loading doses are required. Many anti-VEGF studies used three loading doses because that is about the average number of treatments needed to get a macula dry.
Dr. Heier: If the macula dried up completely after the first injection, then I’ll usually treat at that visit (resulting in two monthly visits), and then extend two weeks.
Dr. Reed: By what increment do you extend the interval when the macula is dry? If there is a recurrence while extending, by how much do you tighten the interval? What is the maximum interval you will extend to?
Dr. Regillo: I extend or reduce by two weeks. However, if a patient can’t be extended beyond six weeks I’ll use one-week increments to extend him as far as I can. So if the patient is recurring at six weeks but dry at four, I’ll try five weeks. Although some patients can extend beyond 12 weeks, I don’t routinely extend beyond 12 weeks. I think you’re starting to roll the dice beyond that, regardless of the drug.
| Take-home Point Treat and extend for neovascular age-related macular degeneration requires a nuanced clinical approach. For example, while a completely dry macula is a goal, at times some fluid is tolerable—depending on the patient and clinical situation. Scenarios such as a recent cardiovascular event may dictate changing from treat and extend to as-needed treatment. In a nuanced approach, patient desires can play a significant role in treatment decisions. |
New Diagnosis of Wet AMD
Dr. Reed: Do you order a fluorescein angiogram for all new cases?
 |
| Figure 1. Carl Regillo, MD, FACS, delivers anti-VEGF treatment to a patient at Wills Eye Hospital. Roger Barone/Wills Eye Hospital |
Dr. Regillo: I still routinely get an FA. There are some circumstances when I may not, but I like to be sure that I am dealing with wet AMD and not a condition that mimics wet AMD.
Dr. Heier: I do FA 100 percent of the time. I do it to understand exactly the characteristics of the pathology we’re dealing with. I do it to make sure we’re not missing other diseases, although that is less likely with spectral-domain OCT. It’s less likely you’ll miss cystoid macular edema or a small branch vein occlusion or macular telangiectasia, but it happens.
I like to have the FA every time to document the pathology at the beginning. After that, I only repeat the FA if something has changed significantly or if the response is not what I would expect. For example, suppose I don’t get a good response to bevacizumab (Avastin, Genentech), switch to aflibercept and still don’t get a great response. I might repeat the FA and perform indocyanine green angiography as well.
Extension Despite Fluid or Blood?
Dr. Reed: Do you ever tolerate any fluid? For example, a recent consensus article suggested that two weeks of stable fluid on OCT would meet criteria for extending.6 Do you agree with this?
Dr. Heier: Obviously my goal is to have the macula completely dry, but there are times I do tolerate fluid. If the macula does not dry out after the first few injections, I’m almost certainly still at a four-week interval. If I bring that person back at two weeks and the OCT looks the same, the fluid is likely relatively stable. I’ll look at the OCT from when the patient was first diagnosed with wet AMD. If those initial scans were much worse and have now stabilized, I’ll slowly extend, watching that fluid very carefully. That is a patient where instead of extending by two-week increments, I might extend by one week.
If the patient has significantly less fluid at two weeks than at four weeks, I would try increasing the dose of the injection at the next visit. We have substantial safety data on increased doses of both ranibizumab (Lucentis, Genentech)7 and aflibercept,8 and I will occasionally increase the dose by 50 to 100 percent from the same vial.
|
| Figure 2 (top). A small sliver of subretinal fluid persists despite six monthly aflibercept injections. Visual acuity is 20/40. Figure 3 (middle). A small pocket of subretinal fluid at the edge of a pigment epithelial detachment may not necessarily indicate true choroidal neovascular activity. Figure 4. Small intraretinal cysts over an area of fibrosis persist despite eight monthly aflibercept injections. Visual acuity is 20/40. |
Dr. Regillo: There are scenarios where the fluid is simply resistant to treatment. For example, in some patients, a small sliver of subretinal fluid overlying subretinal fibrosis will never completely go away (Figure 2). Small pockets of subretinal fluid at the edge of pigment epithelial detachments (PEDs) often don’t indicate activity and are tolerated well (Figure 3). Small cysts can exist over fibrosis or over atrophy and do not necessarily indicate true choroidal neovascular (CNV) activity (Figure 4).
These examples of treatment-resistant fluid may be well-tolerated as long as there are no signs of true progression: vision isn’t worsening and the CNV complex isn’t growing. Repeating the FA can be valuable here. That’s another benefit of having the baseline FA to compare with. If the disease is optimally controlled, you shouldn’t see CNV growth. And if you’re not seeing CNV growth, but you’re seeing just a small amount of fluid that seems to be well tolerated, then it may be reasonable to not only tolerate it at a given interval but to also extend out as long as nothing changes.
Dr. Heier: Another modality that we are using and learning more about is OCT angiography. We are looking to see if there is a neovascular complex that is still active.
Dr. Reed: Suppose a patient could have injections every eight weeks with a small amount of persistent subfoveal subretinal fluid or injections every four weeks and be completely dry, with the same vision. Do you think the risk associated with doubling the injections is worth it?
Dr. Regillo: I wouldn’t tolerate the fluid. I would try to extend to a five- or six-week interval and keep the macula completely dry. The recurrent fluid is not a good sign. We know that PRN or intermittent therapy doesn’t work as well across the board because you’re allowing for recurrences.2 Over time, recurrent fluid is not well-tolerated and it could also be a sign of CNV growth, which you can’t necessarily recover from
We must think long term for this disease; it’s for life for most of these patients. I tell every patient: We set out to get the best results with the fewest number of treatments. In general, allowing multiple or significant recurrences does not get the best results.
Dr. Reed: Suppose there is fluid and a small amount of intraretinal blood at the initial presentation. After the first injection, the fluid goes away but the small amount of intraretinal blood persists. Would you extend yet or wait until the blood is completely resolved?
Dr. Regillo: Usually I aim to get all signs of exudation to resolve before starting to extend. But I will sometimes tolerate a small amount of hemorrhage, especially if it’s getting smaller and everything else has been dry for a while. As long as there is not new or increasing hemorrhage, I will tolerate some hemorrhage that remains after the initial hemorrhage and start to extend.
Dr. Heier: Absolutely. Often there are hemorrhages in lesions that persist for months, despite a dry OCT. Sometimes I’ll look at the OCT angiogram, and if I don’t see an active neovascular complex, I would extend.
Dr. Reed: If there is an RPE tear with hemorrhage, does that hemorrhage indicate activity in the same way as hemorrhage from CNV without a tear? Would you be more willing to tolerate the hemorrhage from a tear not involving the fovea than hemorrhage from CNV without a tear?
Dr. Heier: These are complicated cases and I watch them even more carefully. I’ve seen a number of these patients sent to me over the years where they had a tear and were ignored after the event. They were treated a little and extended more rapidly than I would have done, and then they had more bleeding. So I do watch these more carefully and make sure I am very aggressive with them as they heal. But at some point, very far down the road, if there is still some residual hemorrhage I may tolerate it.
No Recurrence at 12 Weeks: Now What?
Dr. Reed: How long do you keep patients at 12-week intervals before giving them a trial off injections? How frequently do you follow them once you do the trial off injections?
Dr. Regillo: Early on in the treat-and-extend paradigm, I would tell patients that if we can get to 12 weeks, the drug will have been long gone, and they will have shown they are stable without it. I used to routinely have patients come off treatment. Well over half the time they would eventually recur. Many other retina specialists noticed the same thing happening, so I very rarely stop treatment once a patient reaches a 12-week interval.
Another reason to keep them at 12 weeks is because I want to keep a close watch on both eyes. These people are at very high risk of having wet AMD in their fellow eye. And so I like having them come in at this interval, anyways. Sometimes I’ll extend them to 14 weeks or I’ll tell them 12-14 weeks is acceptable. I won’t be as strict, for example, if it’s a snow day or if the patient has scheduling issues.
Perhaps in the future there will be drugs that last longer. Two drugs currently in Phase III trials, Allergan’s Abicipar and Novartis/Alcon’s Brolucizumab (RTH258), may achieve greater durability than the drugs we use now.
Dr. Heier: I agree with Dr. Regillo. In the past I was more likely to stop treatment than I am now. The data convincingly shows that the less regular therapy we do, the worse patients do in general. If it’s a monocular patient whose fellow eye had a neovascular event, I will never stop injecting the good eye. Some of those patients I may even keep at eight-week intervals, depending on what type of event they had.
Bilateral Wet AMD, Each Eye with Unique Needs
Dr. Reed: Suppose one eye requires injections every four weeks and the other requires injections every six weeks. Assuming you do bilateral injections, how do you handle this situation?
Dr. Regillo: I leave it up to the patient. I try to find some common ground and make it easy for the patient. If the patient doesn’t mind coming more frequently, I will treat each eye on separate visits, but often the eye that requires more frequent injections drives the interval. If one or both of the eyes are extending, I will try to get them in sync if I can. There may be a time when I’ll accelerate the extension in one eye and slow down the extension in the other to get them in sync.
When to Retry an Extension?
Dr. Reed: Suppose a patient had a history of recurrence at 10 weeks and has been stable receiving injections every eight weeks. How long would you keep him at eight weeks before you try to extend again?
Dr. Heier: I don’t know what the right answer is, and it probably depends on the patient. It would be a minimum of six months and it might be even longer. It depends on what happened during the recurrence.
If it was a very subtle recurrence, perhaps I would try to extend again after four to six more injections. If the recurrence was fairly significant, where they had a loss of vision, or bleeding, then it might be even longer.
Dr. Regillo: It’s variable and a hard question to answer precisely. The fellow eye plays a role in the decision. As Dr. Heier noted, what kind of recurrence they had also plays a role. It also depends on how good their vision is. If they have poor vision and they’re not noticing these recurrences, then I may be more inclined to rechallenge them. But if they have good vision and they are exquisitely sensitive to any changes, I’d be less inclined.
I was involved in that consensus article you referred to and this was the one question that had the biggest debate. Our consensus was that you could consider rechallenging the patient after two or three consecutive visits with maximal response.
Situations for Less Frequent Treatment
 |
| Figure 5. En face optical coherence tomography shows a large pigment epithelial detachment (top), while a cross-sectional OCT image shows the large pigment epithelial detachment with subretinal fluid at its crest. |
Dr. Reed: Are there scenarios where you would attempt to minimize injections even further, perhaps even use a PRN regimen?
Dr. Regillo: There are a couple scenarios where I might deviate from treat and extend and treat PRN. One is a recent stroke or myocardial infarction, where I’m worried about exposure of the drug systemically, even though I think the risk is very low. I would have a dialogue with the patient and say, “There is a small chance this could exacerbate your vascular disease and I want to try something to minimize the exposure even more than what we are already doing. Because with treat and extend we are already trying to minimize the exposure of the drug.” So I might skip a dose and see what happens.
I might also use this approach in a patient with a history of endophthalmitis if the patient had a big scare. Especially in the process of trying to get the endophthalmitis to resolve, we’re often taking a break from injections at that time. However, in the fellow eyes of patients who have had severe endophthalmitis, I still use TAE; I am not willing to use a strategy that will result in worse vision in their good eye.
Dr. Heier: The one that is the most important is the recent stroke or myocardial infarction. Both Dr. Regillo and I have given safety talks on these drugs and I think these drugs are remarkably safe. If there is an increased risk in patients with a recent cardiovascular event, that risk is very low.
Still, the concept of a cerebrovascular accident or cardiovascular event that may be related to our treatment, however unlikely, is concerning. I’ll always have the discussion with these patients, telling them, “There’s little to no evidence that these injections increase your risk if you haven’t had a recent stroke or myocardial infarction, but there may be a slightly increased risk if you have. It’s hard to know for sure because patients receiving these drugs are already at increased risk.”
In this scenario, if the patient has good vision in both eyes and has been very well-controlled, I might try PRN treatment. If the patient has good vision in only one eye and the other eye has poor vision from AMD, or any other cause, I’m unlikely to stop treatment. In that case, I will have an in-depth discussion with the patient and his family. And I will bring into the conversation their neurologist or their cardiologist or their primary-care doctor because these patients are at high risk and I want them to understand that they are already at high risk because they’ve had a recent stroke. Many patients are already being anticoagulated, so their risk of another event may be relatively low, yet their risk of vision loss and resulting loss of independence is high.
If they’ve had a very mild endophthalmitis, I probably won’t change very much. We’ll discuss it and say, “This was a very rare occurrence and the likelihood of it happening again is low. The likelihood of losing vision from under-treatment is not insignificant.” And so we will likely continue. But if the patient had severe endophthalmitis with significant vitreous debris remaining, and the view of the posterior pole is poor, then often I will delay therapy.
When RPE Tear Is a Concern
Dr. Reed: What about the concern for causing an RPE tear in patients with a high PED (Figure 5)? And the concern for injections causing geographic atrophy? Does either of these concerns tempt you to treat less than traditional TAE?
Dr. Regillo: I definitely tell patients with a high PED that tears can occur, and we don’t know whether it’s precipitated by the drug or not. It can happen at any time. And we’ve all seen them happen without injections. So I’m not even sure of the causal relationship. I’m worried, but I don’t deviate in this scenario.
We don’t have evidence that these drugs are accelerating geographic atrophy. We probably never will. I don’t reduce treatments because of this concern. However, if a patient whose wet component is under control is losing vision because his atrophy is becoming subfoveal or expanding, I won’t reduce the interval. That’s an important point to keep in mind when vision changes are affecting your decision to treat and how often.
Dr. Heier: I’m actually afraid to stop treating wet AMD patients with a large PED.
In patients with geographic atrophy, I will try to determine why the patient is losing vision. A lot of times patients who are doing very well with injections will complain of vision loss from the atrophy. That’s a case where I’m concerned that the treatment could be accelerating its progression. If the fellow eye looks similar, I think that is their natural history. But still this is the patient for whom TAE is very valuable. Even in these situations I rarely go beyond three months.
Dr. Reed: If a patient has good vision in one eye but 20/400 in the other eye, and you’re only injecting the bad eye, would you ever be less aggressive? For example, if the patient requires monthly injections to maintain a dry macula, would you continue on this regimen to maintain the 20/400 vision in the eye they’re not using everyday?
Dr. Heier: This is a good question: When do you stop? If they are 20/400 and are stable, I’ll tell patients there are two reasons to continue treatment. One is to make them better and the other is to prevent them from getting worse. If they have a reasonably small to moderately sized scar and whenever I stop they leak and their vision gets worse, then I’m going to keep treating them.
Although we’re not helping them to improve, we are preventing them from getting worse, and I’ll continue to treat.
On the other hand, if we hold on treatment and their vision doesn’t change, I might stop treatment. If we hold treatment and they get leakage and decreased vision and aren’t bothered by it, I may consider stopping.
Dr. Reed: Suppose you hold injections in such a patient—one with poor vision who gets a recurrence of fluid, but no change in vision. Are you concerned that a decade with fluid might deteriorate his or her vision further than if you had continued injections?
Dr. Heier: I am, which is why I try to gauge whether I’m still making a difference with injections. If I can show I am making a difference, it makes a stronger case for continuing treatment. But some patients do tire out. Although I would like to be able to maintain that 20/400 vision, the patient’s desires also play a role.
Also, we’ve all seen 20/400 eyes with relatively manageable scars and 20/400 eyes with large scars that are far less functional. The relatively wide range in what 20/400 means in terms of daily function also influences patients’ desires to continue or stop treatment. RS
Acknowledgment: The authors would like to acknowledge the contributions of Francis Char DeCroos, MD, of Southeastern Retina Associates, Chattanooga, Tenn.; and Murtaza Adam, MD, vitreoretinal fellow at Wills Eye Hospital. Both Drs. DeCross and Adam disclosed receiving research grants from Regeneron.
REFERENCES
1. Spaide RF. The as-needed treatment strategy for choroidal neovascularization: a feedback-based treatment system. Am J Ophthalmol 2009;1481:1-3.
2. Comparison of Age-related Macular Degeneration Treatments Trials (CATT) Research Group, Martin DF, Maguire MG, Fine SL, et al. Ranibizumab and bevacizumab for treatment of neovascular age-related macular degeneration: two-year results. Ophthalmology. 2012;119:1388-1398.
3. Heier JS, Brown DM, Chong V, et al. Intravitreal aflibercept (VEGF trap-eye) in wet age-related macular degeneration. Ophthalmology 2012;11912:2537-2548.
4. Rofagha S, Bhisitkul RB, Boyer DS, Sadda SR, Zhang K; SEVEN-UP Study Group. Seven-year outcomes in ranibizumab-treated patients in ANCHOR, MARINA, and HORIZON: a multicenter cohort study (SEVEN-UP). Ophthalmology. 2013;120:2292-2299.
5. American Society of Retina Specialists Annual Preferences and Trends Survey, 2015. Available at: http://www.asrs.org; access for members only.
6. Freund KB, Korobelnik JF, Devenyi R, et al. Treat-and-extend regimens with anti-VEGF agents in retinal diseases: A Literature Review and Consensus Recommendations. Retina 2015;358:1489-1506.
7. Ho AC, Busbee BG, Regillo CD, et al; HARBOR Study Group. Twenty-four-month efficacy and safety of 0.5 mg or 2.0 mg ranibizumab in patients with subfoveal neovascular age-related macular degeneration. Ophthalmology. 2014;121:2181-2192.
8. Heier JS, Boyer D, Nguyen QD, et al.; CLEAR-IT 2 Investigators. The 1-year results of CLEAR-IT 2, a phase 2 study of vascular endothelial growth factor trap-eye dosed as-needed after 12-week fixed dosing. Ophthalmology. 2011;118:1098-1106.



